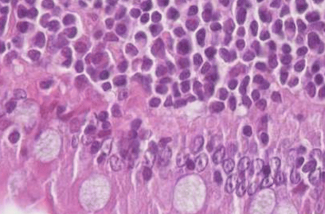

To help support both our members, and the wider veterinary profession, we have created a library of fantastic veterinary resources to help in and out of practice. The covers everything from our medicines guide and client information leaflets, to our position statements and jobs board.